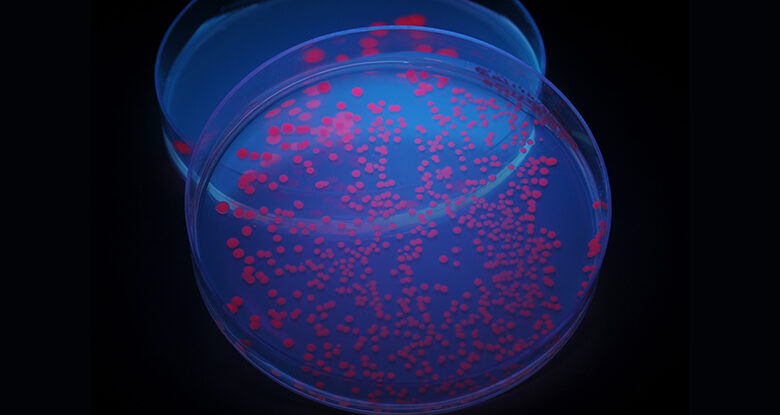

مقالات
أصحاب نظرية المؤامرة يستفيدون من مرض إكس للإبادة الجماعية
أصحاب نظرية المؤامرة يستفيدون من مرض إكس للإبادة الجماعية
مصر:إيهاب محمد زايد
“المرض X”، الذي صاغته منظمة الصحة العالمية للإشارة إلى جائحة افتراضي في المستقبل، يقع في قلب عاصفة من المعلومات المضللة التي يعمل منظرو المؤامرة الأمريكيون على تضخيمها – والاستفادة منها.
ووجد مدققو الحقائق في وكالة فرانس برس أن الأكاذيب، بما في ذلك أن العامل الممرض غير المعروف يشير إلى مؤامرة نخبوية لإخلاء الأرض، يبدو أنها نشأت في الولايات المتحدة لكنها امتدت إلى آسيا بلغات إقليمية متعددة.
وتهدد المعلومات الخاطئة سريعة الانتشار، والتي يقول الخبراء إنها توضح مخاطر انخفاض الإشراف على المحتوى على مواقع التواصل الاجتماعي، بتغذية التردد بشأن اللقاحات وتعريض الاستعداد لطوارئ الصحة العامة للخطر بعد أربع سنوات من تفشي مرض كوفيد-19.
ومما يثير المخاوف بشأن المرض X، يستفيد أصحاب النفوذ اليميني في الولايات المتحدة أيضًا من الأكاذيب من خلال بيع مجموعات طبية تحتوي على ما يسميه خبراء الصحة علاجًا غير مثبت لفيروس كورونا.
وقال تيموثي كولفيلد من جامعة ألبرتا في كندا لوكالة فرانس برس إن “تجار المعلومات المضللة يحاولون استغلال نظرية المؤامرة لبيع المنتجات”.
“غالبًا ما يكون هذا هو مصدر دخلهم الأساسي. الصراع عميق. وبدون الترويج للخوف الخالي من الأدلة حول اللقاحات والمؤامرات الحكومية، لن يكون لديهم سوى دخل ضئيل أو معدوم”.
انطلقت نظريات المؤامرة بشكل خاص بعد أن عقد المنتدى الاقتصادي العالمي – الذي يجذب المعلومات المضللة – لجنة “التحضير للمرض X” في يناير/كانون الثاني، وركزت على جائحة محتمل في المستقبل.
بيع المنتوجات
ادعى أليكس جونز، مؤسس موقع InfoWars الذي حقق الملايين من خلال نشر نظريات المؤامرة حول عمليات إطلاق النار الجماعية وكوفيد-19، كذبًا على وسائل التواصل الاجتماعي أن هناك خطة عالمية لنشر المرض X باعتباره “سلاح قتل للإبادة الجماعية”.
ومع انتشار المؤامرة إلى الصين، زعمت المنشورات التي تمت مشاركتها على TikTok وX (تويتر سابقًا) أن الحكومة الصينية كانت تطرح أفرانًا متنقلة لحرق الجثث للتعامل مع “الوفيات الجماعية”.
ولكن باستخدام البحث العكسي عن الصور، وجد مدققو الحقائق في وكالة فرانس برس أن مقاطع الفيديو الموجودة في المنشورات أظهرت بالفعل خدمات حرق جثث الحيوانات الأليفة.
في أكتوبر الماضي، فضح مدققو الحقائق التابعون لوكالة فرانس برس منشورات على الإنترنت في ماليزيا تزعم أن الممرضات يُجبرن على أخذ لقاح غير موجود للمرض X.
ادعى طبيب القلب الأمريكي بيتر ماكولو، المعروف بنشر معلومات مضللة عن كوفيد-19، دون دليل على أن المرض X “من المتوقع أن يتم هندسته في مختبر بيولوجي”.
وقد قدم هذا الادعاء على الموقع الإلكتروني لشركة The Wellness Company، وهي شركة توريد المكملات الغذائية ومقرها الولايات المتحدة حيث يشغل منصب كبير المسؤولين العلميين.
لحث الناس على “الاستعداد” للمرض X، يقدم الموقع “مجموعة أدوات الطوارئ الطبية” بحوالي 300 دولار، والتي تحتوي على أدوية بما في ذلك الإيفرمكتين، وهو علاج غير مثبت لـ Covid-19.
كما قام موقع Gateway Pundit، وهو موقع يميني معروف بنظريات المؤامرة، بالترويج للمعدات في رسالة دعائية بعنوان “”المرض X” – هل يخطط دعاة العولمة لجائحة أخرى؟”
وجاء في الرسالة: “لا تكن مستعدًا”، مما يقود القراء إلى رابط لطلب المجموعات.
المعلومات الخاطئة تمر دون منازع
وقالت جولي ميليكان، نائبة رئيس منظمة “ميديا ماترز” اليسارية، لوكالة فرانس برس إن “نشر نظريات المؤامرة من أجل كسب المال هو احتيال راسخ لدى اليمين”.
وأضافت أن “الأشخاص الذين يرجح أن ينشروا نظريات المؤامرة” حول موضوعات مثل المرض X، “يبحثون أيضًا عن طريقة للاستفادة من جمهورهم لتحقيق الربح منه”.
ولم تستجب شركة Wellness Company وGateway Pundit لطلبات وكالة فرانس برس للتعليق.
يبدو أن الكثير من المعلومات الخاطئة لا يمكن التصدي لها، حيث تعمل منصات مثل X على تقليص الإشراف على المحتوى في مناخ من خفض التكاليف الذي أدى إلى إضعاف الثقة وفرق السلامة.
وقالت جينيفر رايش، عالمة الاجتماع في جامعة كولورادو دنفر، إن نظريات المؤامرة مبنية على التردد المتزايد بشأن اللقاحات منذ كوفيد-19، والذي من المرجح أن يكون له آثار “بعيدة المدى” على الصحة العامة.
وقال رايخ لوكالة فرانس برس: “منذ كوفيد، شهدنا تراجعا في الدعم للقاحات الأطفال وزيادة الدعم في المسوحات المتعلقة بحقوق الآباء في رفض اللقاحات لأطفالهم”.
وتعهد بعض المؤمنين بمؤامرات المرض X برفض اللقاحات المستقبلية، وفقًا لمنشورات على وسائل التواصل الاجتماعي تتبعتها وكالة فرانس برس، وهو موقف قد يحد من الاستجابة لحالات الطوارئ الصحية الحقيقية.
وقال تشونهوي تشي، أستاذ الصحة العالمية في جامعة ولاية أوريغون، لوكالة فرانس برس: “يمكن أن تؤدي المعلومات المضللة أيضًا إلى قيام بعض شرائح السكان باتخاذ إجراءات غير فعالة أو حتى ضارة أثناء الوباء”.
“يمكن أن يصبح عائقًا كبيرًا أمام المجتمع ليكون استباقيًا في الاستعداد والوقاية من الأمراض المعدية الناشئة.



